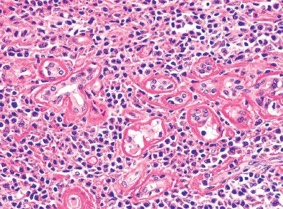

Полный доступ позволяет:
- Решать тесты онлайн без ограничений;
- Убрать всю рекламу на сайте;
- Добавлять вопросы в избранное;
- Сохранять прогресс обучения;
- Сохранять результаты пробных экзаменов;
- Просматривать все допущенные ошибки в вопросах.
На вопрос ещё не добавлено комментариев. Нашли ошибку или считаете, что вопрос некорректно составлен? — расскажите об этом.
Оставлять комментарии могут только зарегистрированные пользователи
Войти на сайтПрогресс: 24% (23/94)?
Приобретите услугу «полный доступ», чтобы выполнить данное действие
Полный доступ позволяет:
Комментарии (0)